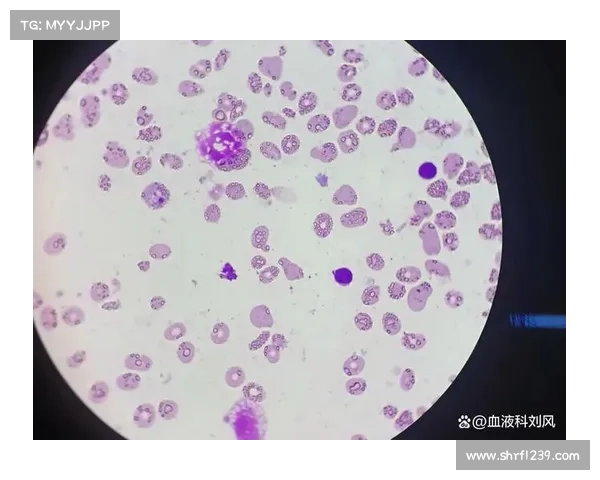
何为再生障碍性贫血

对于贫血大家都不会陌生,指人体血红蛋白相对较低,一种常见的症状。其实贫血的类型是很多的比如说本文要为大家介绍的再生障碍性贫血,那么什么是再生障碍性贫血,今天我为大家就该病的特点及症状进行介绍。
先来了解一下什么是贫血。
通常所指的贫血是指外周血红细胞容量减少或血红蛋白下降,低于正常范围下限的一种病态。国海平面地区,当成年男子血红蛋白120g/L成年女性(非妊娠)110g/L孕妇100g/L即可诊断贫血。贫血相当多见,但部分患者因症状较轻未做血常规检查而漏诊,或误诊为年老体衰、慢性疲劳综合征及工作倦怠综合征。
再生障碍性贫血是一组由多种病因引起的骨髓造血功能衰竭,以造血干细胞损伤、外周血全血细胞减少为特征的难治性血液病,临床上常表现为贫血、出血和感染;本病病理生理机制十分复杂,治疗难度大,疗效低。
再生障碍性贫血的起病缓慢,以贫血为主要临床表现,出血多限于皮肤黏膜,切不严重,可并发感染,但常以呼吸道为主,容易控制。病程多在4年以上,甚至可长达10年之久。若治疗得当,坚持不懈,大多可治愈,但也有病人迁延多年不愈。少数病人可急性发作,病情急转直下,常与感染有关。
pc28开奖网站以上是对再生障碍性贫血的介绍,相信通过简单的介绍,现在大家对再生障碍性贫血应该有了一个初步的再生障碍性贫血的病程长,治疗疗程也不知,所以治疗必须要坚持。治疗时一定要选择正规的专业医院,才能使治疗的安全性和科学性得到保证。





